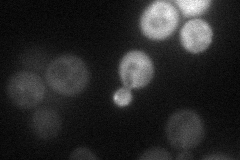
YGR146C
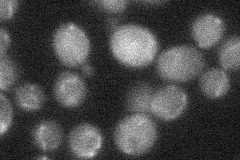
YGR146C
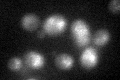
YGR146C
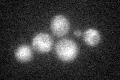
YGR146C

View description
Protein of unknown function, affects chronological lifespan; induced by iron homeostasis transcription factor Aft2p; multicopy suppressor of temperature sensitive hsf1 mutant; induced by treatment with 8-methoxypsoralen and UVA irradiation
Localization:
Intensity:
Fold change:
Significance:
-
C’ GFP library in SD

below threshold18.11 -
N' NOP1pr-GFP in SD
cytosol23.8059 -
N' TEF2pr-mCherry in SD

below threshold4.84133 -
N' NATIVEpr-GFP in SD
below threshold23.1432 -
N' TEF2pr-VC and Cyto-VN in SD

#N/A0 -
C’ GFP library in SD+DTT
cytosol25.681.41No -
C’ GFP library in SD+H2O2
cytosol18.171No -
C’ GFP library in Starvation Media

cytosol22.371.23No -
C’ GFP library on the background of Pup2-DaMP

below threshold -
C’ GFP library on the background of CCT mutant

below threshold18.03290.995273No
